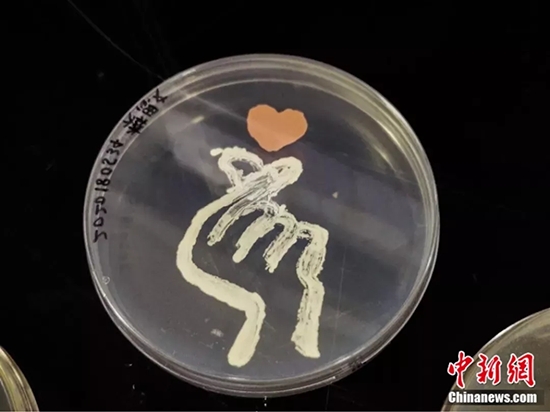
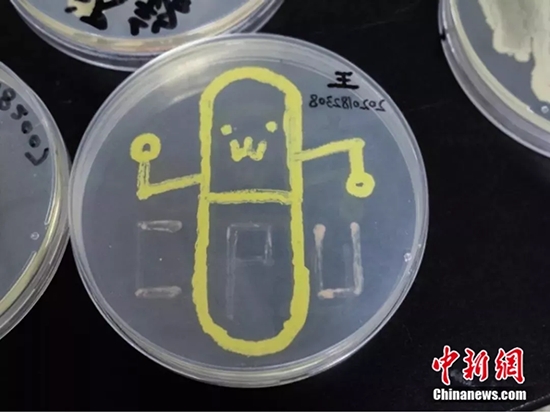
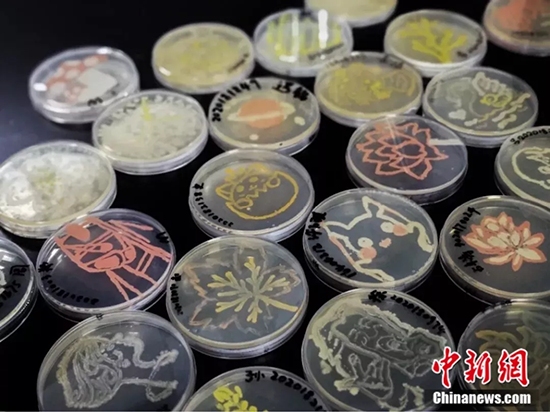
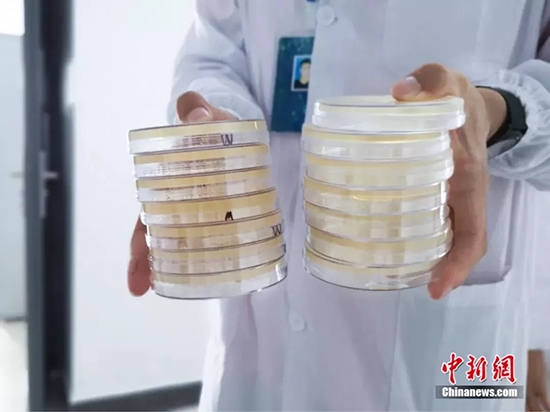

細(xì)菌や真菌と聞いても、それがどんな形をしたものだったか中學(xué)の生物の教科書(shū)で見(jiàn)ただけと言う人がほとんどだろう。だが、そんな思わず人々に鳥(niǎo)肌を立たせてしまうような「ちっちゃな細(xì)菌たち」が、なんとステキなアート作品を生み出している。

中國(guó)薬科大學(xué)の學(xué)生たちはこのほど微生物の実験技術(shù)を利用して、細(xì)菌を畫(huà)材に、細(xì)菌培養(yǎng)シャーレをキャンパス代わりにし、細(xì)菌で図案を描いた。

このような奇想天外なアート作品の制作に用いられているのは、微生物の培養(yǎng)と紫外線による消毒細(xì)菌技術(shù)。學(xué)生たちは、事前に図案をデザインしておき、黃色ブドウ球菌や大腸桿菌、枯草菌、サルシナルテア菌などの細(xì)菌群を畫(huà)材として用い、細(xì)菌培養(yǎng)シャーレの中で、用意しておいた図案に基づき、作畫(huà)。その後、37℃の恒溫培養(yǎng)ボックスの中に入れる。すると3日後には黃色ブドウ球菌などさまざまな色や形をした培養(yǎng)菌群が、デザイン通りに成長(zhǎng)し、アートが完成するという訳だ。(編集KM)
「人民網(wǎng)日本語(yǔ)版」2018年11月23日
このウェブサイトの著作権は人民日?qǐng)?bào)社にあります。
掲載された記事、寫(xiě)真の無(wú)斷転載を禁じます。
Tel:日本(03)3449-8257
Mail:japan@people.cn